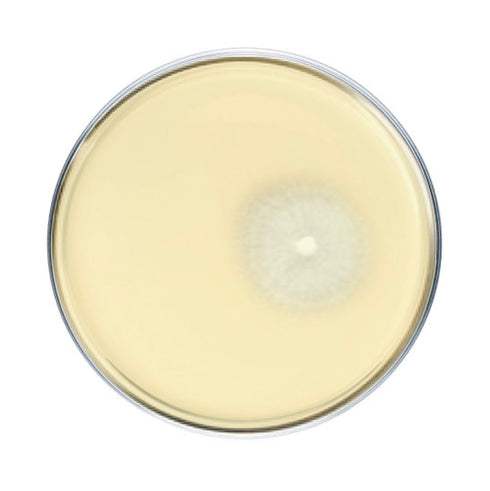

- Home
- Shiitake Mushroom Plate Culture
Shiitake Mushroom Plate Culture

Species difficulty | Intermediate |
Culture format | Agar plate |
Lab skills | Intermediate |
Shelf life | 6 months (refrigerated) |
Plate cultures are ideal for growers looking to make master bags, inoculate grain, make liquid culture, or make more plates.
Our shiitake plates are made to order in our in-house lab using medical-grade petri dishes. If properly stored upon arrival, they have a shelf life of approximately 6 months. Shiitake plates should be stored in the refrigerator to maintain viability. Note that mycelium cultures require basic lab skills. Handle using sterile technique to prevent contamination.
For complete descriptions of available shiitake strains, click on the names below.
-
Lentinula edodes. Our favorite commercial strain for indoor shiitake block production. This strain fruits best at colder temperatures and tends to produce mushrooms with large caps and smaller stems. Our culture is direct from Belgium and retains the highly desired characteristics of this strain. Yield averages are .75-1.5 lb first flush off of 5 lb supplemented sawdust blocks.
-
Lentinula edodes. A variation on commercial indoor shiitake genetics. We've had similar results from this strain as from our '207' strain listed above. We like having multiple varieties of the same species to ensure genetic diversity and reduce the odds of crop failure.
-
Lentinula edodes. Fast spawn run, heavy first flushes, and quick log recovery after fruiting.
-
Lentinula edodes. Warm weather strain that responds well to force fruiting. Grows large, plump mushrooms.
-
Lentinula edodes. A highly productive, cool season fruiter that yields heavier in the spring.
-
Lentinula edodes. Reilable strain, even if the growing conditions and substrate are not perfect. Can tolerate a wider range of temperatures than most shiitake. Produces medium sized caps.